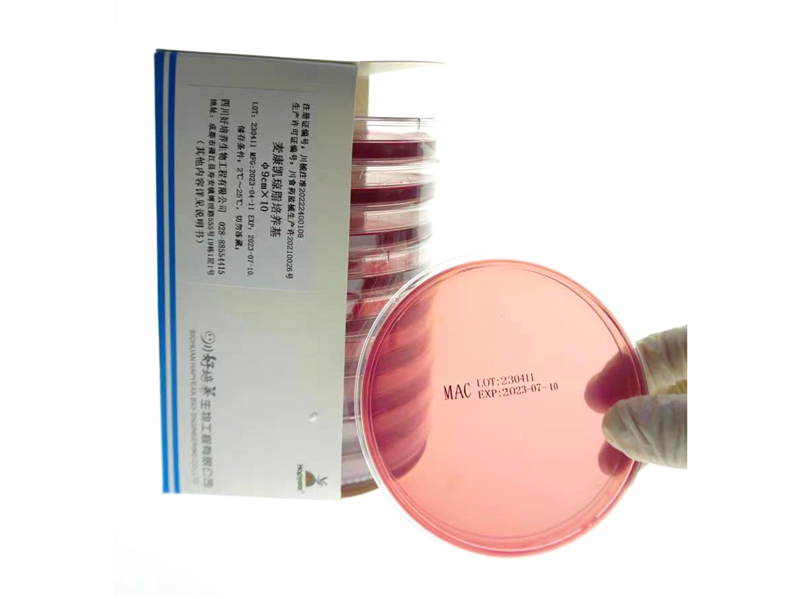
麦康凯琼脂培养基

麦康凯琼脂培养基说明书
【产品名称】
通用名称:麦康凯琼脂平板
【包装规格】
Φ7cm×5、Φ7cm×10、Φ7cm×20、Φ9cm×5、Φ9cm×10、Φ9cm×20
【预期用途】
用于肠道致病菌的分离培养以及非发酵细菌的鉴别。
【检验原理】
该产品中含有适合肠道菌生长的营养物质,作为细菌生长的物质基础。该培养基属弱选择性培养基,利用脱氧胆酸钠选择性抑制革兰氏阳性菌的生长,亦抑制变形杆菌的蔓延生长,有利于革兰氏阴性肠道致病菌的生长,从而达到有效分离培养病原菌的目的;同时,培养基中含有酸碱指示剂中性红及乳糖,细菌发酵乳糖产酸时其菌落为粉红色如大肠埃希氏菌,而细菌不发酵乳糖产酸菌落为无色如伤寒杆菌、痢疾杆菌等肠道致病菌,以此达到细菌的初步区分。
【主要组成成分】
由培养基和塑料培养皿组成。
每1000mL培养基含:
麦康凯琼脂培养基干粉50g(明胶胰酶水解物17.0g、乳糖10.0g、胨3.0g、氯化钠5.0g、脱氧胆酸钠1.5g、结晶紫1mg、中性红30.0mg、琼脂13.5g),纯化水1000ml。
【储存条件及有效期】
储存条件:2℃~25℃,切勿冻藏;效期:3个月。打开内包装后有效期为5天。
【适用仪器】
无
【样本要求】
1.粪便标本:新鲜粪便、肛拭子;
2.应采集新鲜标本:
1)将自然排出的新鲜粪便标本约2g收集于清洁、干燥广口容器中;
2)将无菌拭子插入肛门2~4cm,柔和地旋转拭子采集粪便标本;
3.样本的储存、处理和运输应符合《全国临床检验操作规程》第四版的要求。
【检验方法】
1.开包取出麦康凯琼脂培养基;
2.将标本划线接种于麦康凯琼脂培养基琼脂表面;
3.置35℃~37℃温箱培养孵育18~48小时;
4.观察菌落形态。
【检验结果的解释】
粉红色菌落为能发酵乳糖的细菌;无色菌落为非发酵乳糖的细菌。
【检验方法的局限性】
1.仅适用于肠道致病菌的分离培养及非发酵菌的鉴别。
2.观察菌落特点、挑取可疑菌落作革兰染色只是对细菌分离培养的初步鉴别,最终鉴定结果尚需进一步做生化试验、免疫学试验或质谱等鉴定试验。
【产品性能指标】
1.外观
培养基质地均匀、湿润,无水珠、气泡;厚度均匀;表面平整光滑,无凸起、凹痕或裂痕,颜色为紫红色。
2.微生物限度
培养基在35℃~37℃培养18h~48h,以正常视力检查,可见污染菌生长的培养基产品数应不大于5%。
3.生长试验
培养基接种质控菌株,生长情况应符合下表要求:
质控菌株 | 菌株号 | 观察结果 |
大肠埃希菌 | ATCC25922 | 生长,粉红色菌落 |
奇异变形杆菌 | ATCC49005 | 生长,无色菌落,抑制蔓延 |
鼠伤寒沙门菌 | ATCC13311 | 生长,无色菌落 |
粪肠球菌 | ATCC29212 | 抑制或部分抑制 |
【注意事项】
l本品仅用于体外诊断;
l该产品仅供微生物实验室专业人员按试验操作规程使用;
l全部样品、微生物培养物和接种样品都应该视为具有感染性的,而且应该由受过训练能胜任的技术人员操作。在整个操作中,应该遵循无菌操作和常规处理菌群的注意事项。
l该产品要求防冻、防晒、防破裂、防污染;
l不要使用超过有效期或失效的培养基;
l不要使用不符合标准规定颜色的培养基,因为它们有可能已被污染或失效;
l如出现平皿破损、变形或包装袋开启等包装损坏的情况,不要使用培养基;
l打开内包装膜后,应尽快使用完,一般不超过5天;
l该产品须在生物安全柜下操作;
l该产品只是对细菌的分离培养和初步鉴别;
l该产品为一次性使用,一个培养基只能接种一份标本;
l在做致泻大肠埃希菌微生物检测时,观察结果不但要注意乳糖发酵的菌落,同时也要注意不发酵和迟缓发酵的菌落;
l使用后产品可能具有传染性或污染性,应按传染性或污染性国家安全规章制度要求。废弃物应经高温或高压灭菌后处理。
l轻拿轻放,避免琼脂掉落。
【标识的解释】
提供信息的图标、符号、缩写有:
1.图形:![]() 表示四川好培养生物工程有限公司商标图案;
表示四川好培养生物工程有限公司商标图案;
2.符号:Φ表示直径;
3.缩写:LOT表示批号;MFG表示生产日期;EXP表示有效期。
【参考文献】
YY/T 1169-2009《麦康凯琼脂培养基》
《全国临床检验操作规程》第四版
【基本信息】
注册人/生产企业名称:四川好培养生物工程有限公司
住 所:成都市蒲江县寿安镇博世路555号19栋
联系方式:电话:028-88554415 传真:028-88554415
网址:www.hapyear.com 电子邮件:hapyear@163.com
售后服务单位名称:四川好培养生物工程有限公司
联系方式:电话:028-88554415 传真:028-88554415
网址:www.hapyear.com 电子邮件:hapyear@163.com
生产地址:成都市蒲江县寿安镇博世路555号19栋1层1号
生产许可证编号:川药监械生产许 20210026号
【医疗器械注册证编号/产品技术要求编号】
川械注准20222400108
【说明书核准日期及修改日期】
核准日期:2022.07.05
修改日期:2025.04.17